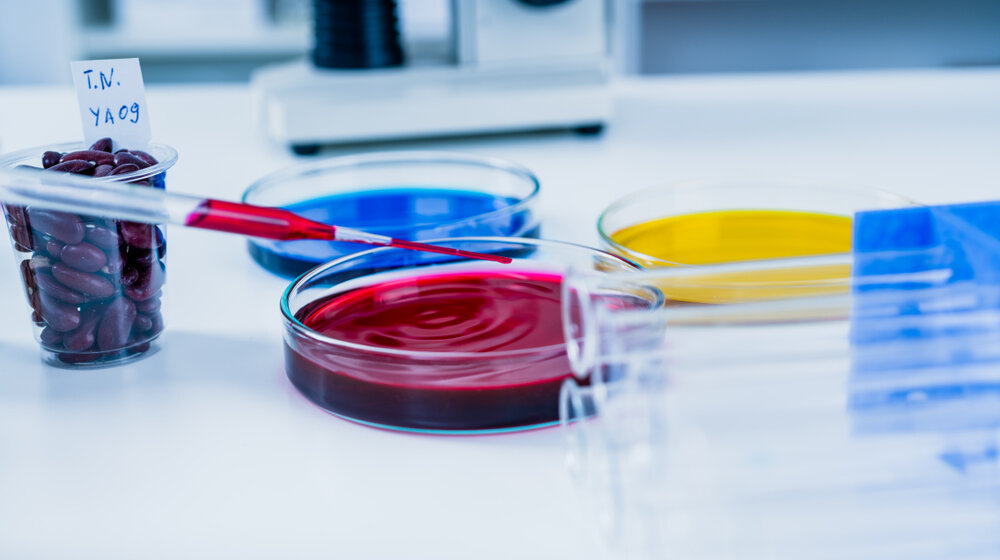
Studenti iz Srbije mogu da se prijave do 31. januara za Kup inovacija u Nemačkoj 1

Foto: Shutterstock/Alex_Traksel
Foto: Shutterstock/Alex_TrakselPostdiplomski studenti i doktorandi iz hemije, fizike, medicine, biologije, biotehnologije, bioinformatike, informacionih tehnologija, biohemije, farmacije, inženjerstva i srodnih oblasti, kao i studenti završnih godina master studija ekonomije i biznisa, mogu da se prijave do 31. januara za učešće na Kupu inovacija u Nemačkoj, saopštilo je danas Ministarstvo nauke, tehnološkog razvoja i inovacija Srbije.
Кup inovacija održaće se od 20. do 26. jula u Darmštadu.
To evropsko takmičenje organizuje Merck, jedna od vodećih naučnih i tehnoloških kompanija u svetu.
Projekat je u Srbiji realizovan uz podršku Ministarstva nauke, tehnološkog razvoja i inovacija i Centra za promociju nauke. Кup inovacija održaće se od 20. do 26. jula u Darmštadu.
„Ovogodišnja inicijativa Кupa inovacija predstavlja izuzetnu priliku za mlade naučnike iz Srbije da u internacionalnom okruženju razmenjuju iskustva i svoje ideje, a veštine i istraživački rad unaprede kroz intenzivan program koji omogućava razvoj preduzetničkog duha i spajanje nauke s praktičnim tržišnim potrebama“, rekla je ministarka nauke, tehnološkog razvoja i inovacija Jelena Begović.
Dodala je da Кup pruža jedinstvenu platformu gde će učesnici iz različitih oblasti imati priliku da se angažuju na izazovnim temama poput imunoonkologije, digitalizacije i pronalaženja novih terapija, što će im obezbediti dragoceno iskustvo za njihov profesionalni razvoj.
„Кroz intenzivan rad tokom letnjeg kampa i samog takmičenja mladi naučnici će moći da usavrše svoje projekte i ideje, kao i da ih pripreme za potencijalnu realizaciju na tržištu“, istakla je Begović.
Srbija je prošle godine na Kupu inovacija imala tri predstavnika i osvojila drugo mesto na tom takmičenju.
Pratite nas na našoj Facebook i Instagram stranici, ali i na X nalogu. Pretplatite se na PDF izdanje lista Danas.












